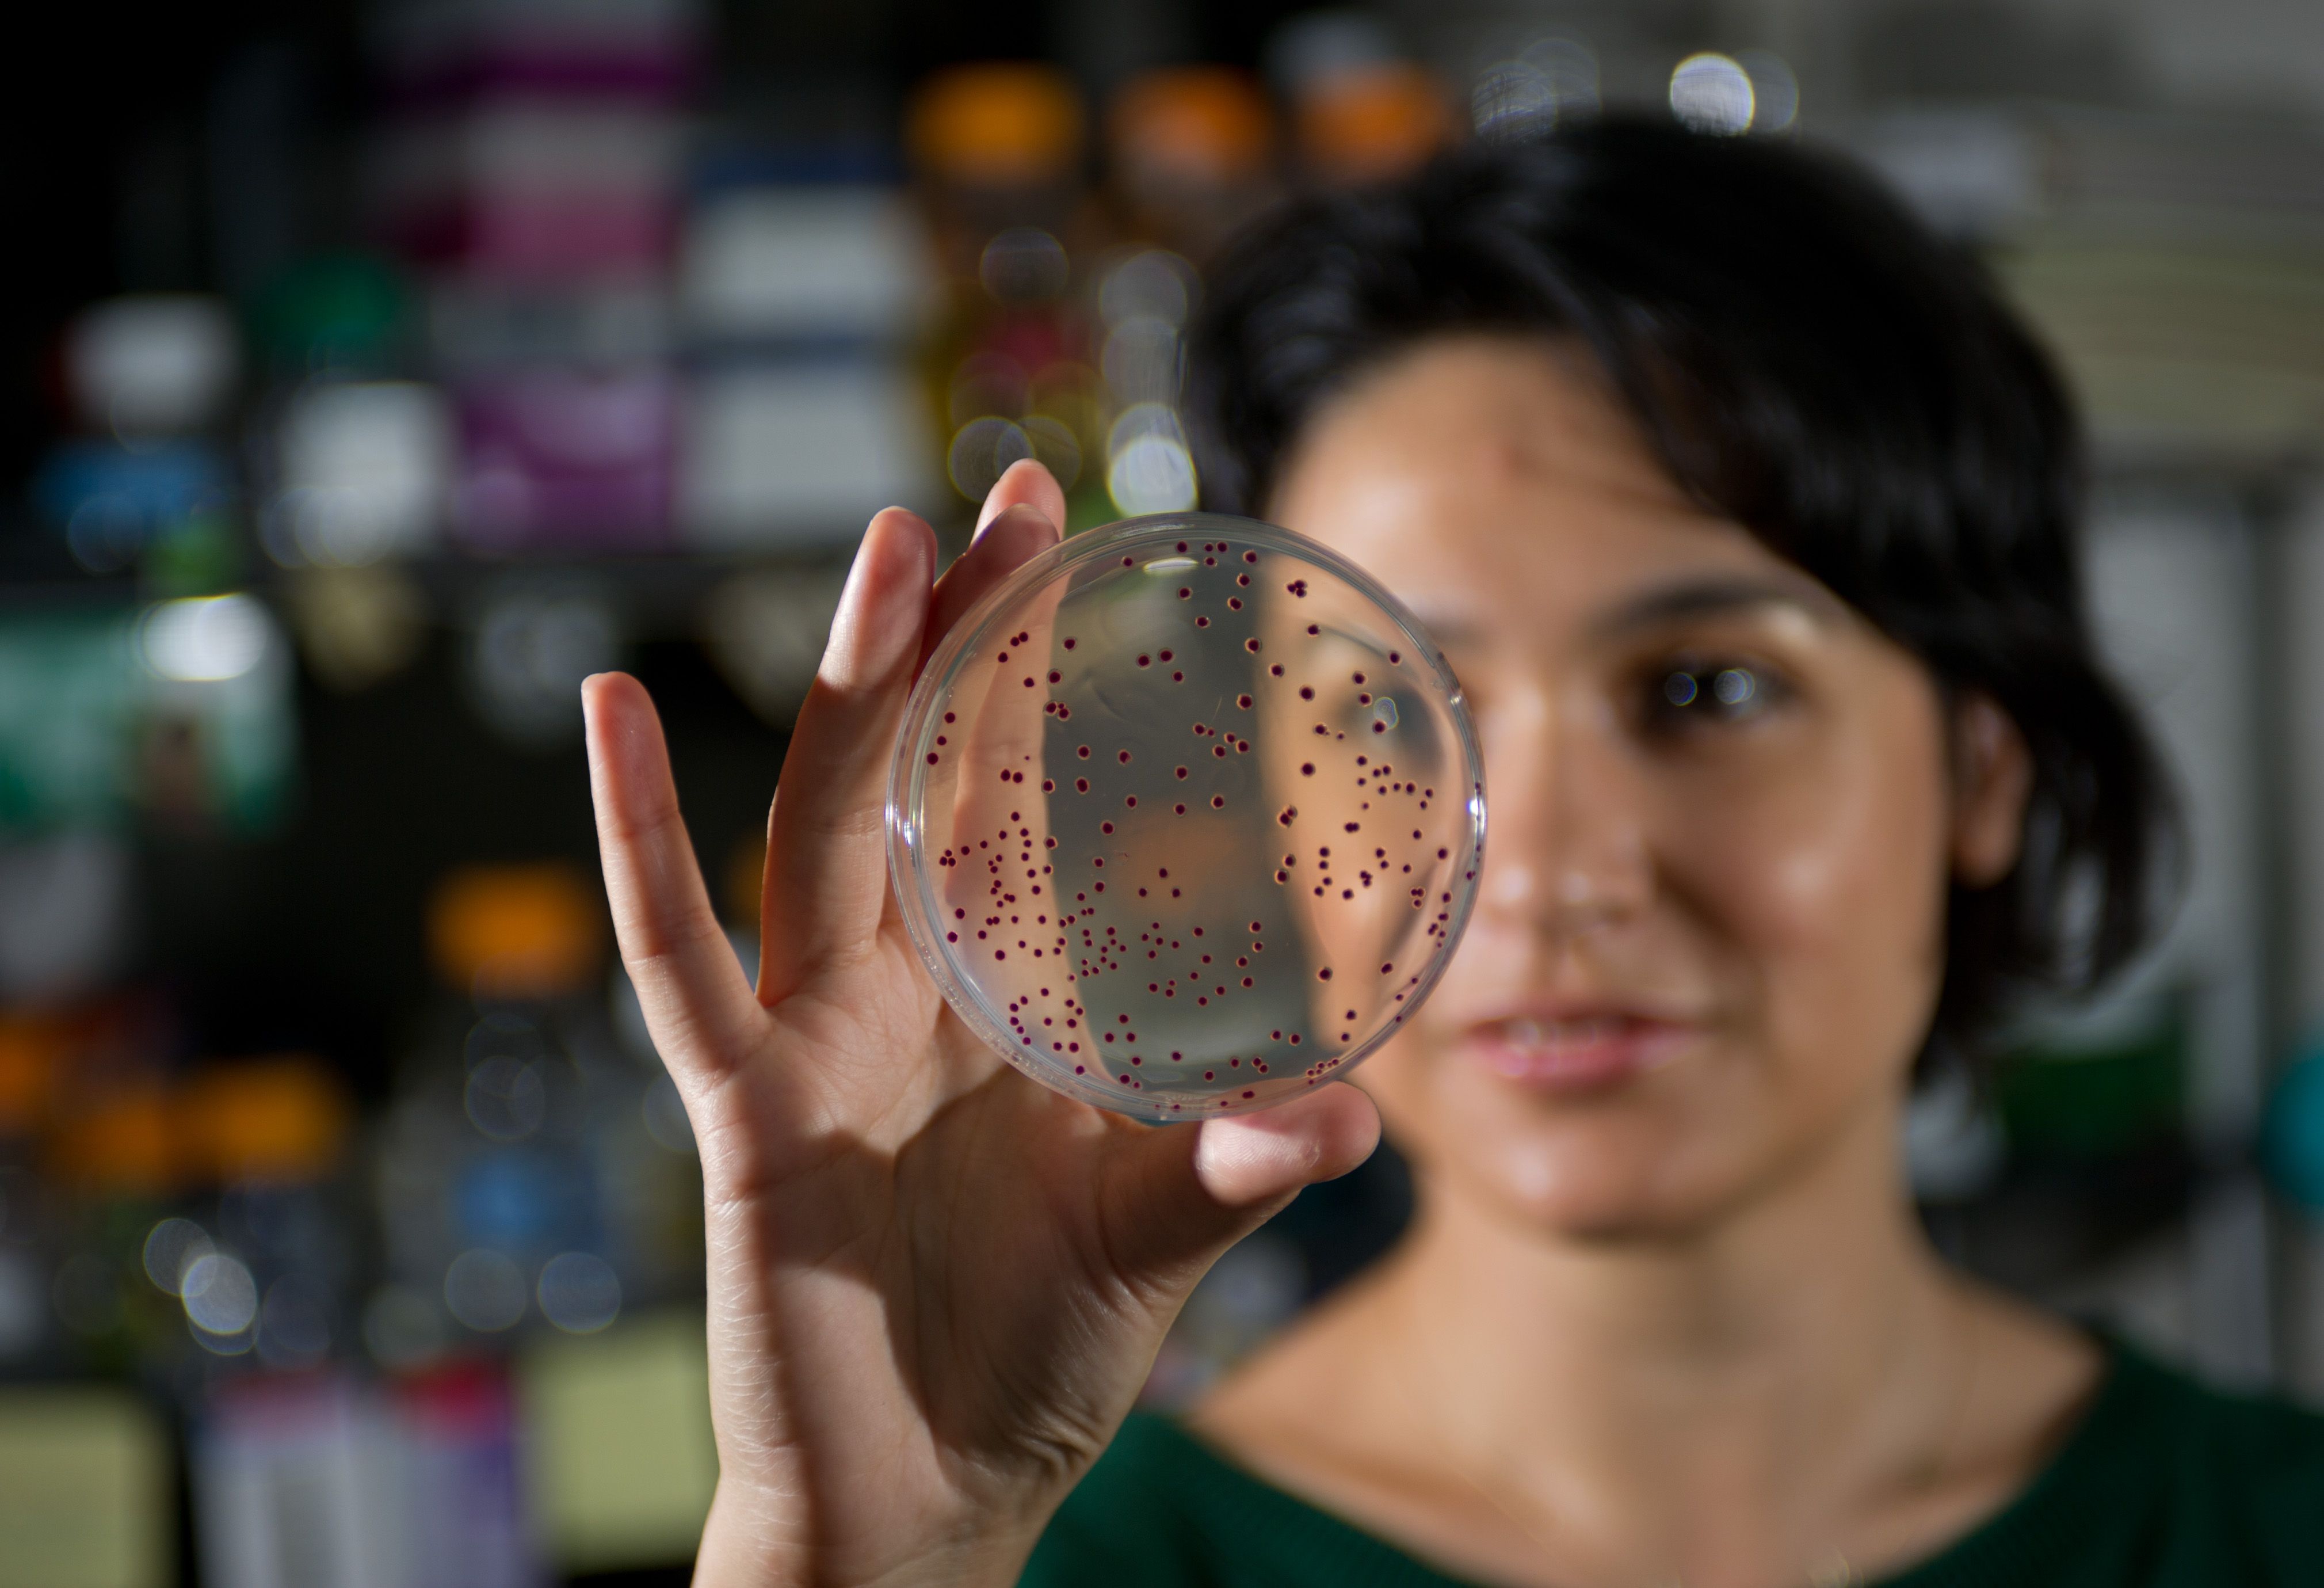
Reseracher looking at her petri dish

Mi ssion
ssion
World-class education and research in the chemical and biochemical sciences, with emphasis on interfaces with questions and applications in biology, materials, energy and sustainability, health care, and engineering.
Vision
The School of Chemistry and Biochemistry will nurture and sustain excellence in research, education, training, and innovation. We will build on our existing collaborative culture and interdisciplinary programs to train the next generation of leaders who will tackle the scientific and technological challenges confronting humankind in the 21st century.
The School of Chemistry and Biochemistry will:
- Provide rigorous, engaging, and meaningful educational and training programs in the chemical and biochemical sciences for our undergraduate students, graduate students, and postdoctoral scholars that integrate education, research and global issues;
- Develop new knowledge and understanding through cutting-edge research that provides a foundation for future intellectual growth and stimulates technological developments that improve the quality of life;
- Foster economic development in the State of Georgia and the United States by providing a diverse, well educated, and highly trained science and engineering workforce, and by the advancement of innovations to industry;
- Create a superior education and research environment that nurtures and sustains a diverse community of students, faculty and staff reflecting the diversity of the nation;
- Promote a greater understanding of science amongst its stakeholders and the general public.
Core Values
Activities in the School of Chemistry and Biochemistry are guided and shaped by a set of core values:
- Excellence in all facets of what we do
- Respect for the diverse roles and backgrounds of all members of the community
- Holistic training to prepare our constituency for future challenges
- Maintenance of the highest level of integrity in all pursuits
- Leadership by example in education and research
- Understanding the significance of our activities in the context of the Institute and the world around us.
Programs
The School of Chemistry and Biochemistry offers B.S. degrees in both chemistry and biochemistry, a M.S. degree in chemistry, and a Ph.D. degree in chemistry. We currently have ~400 undergraduate majors and ~170 graduate students who are largely working toward Ph.D.s. Our graduate students, many of our undergraduates, and our ~80 PhD scientists are engaged in wide-ranging research projects that ;are supported by ~$20 million/year from external sponsors.